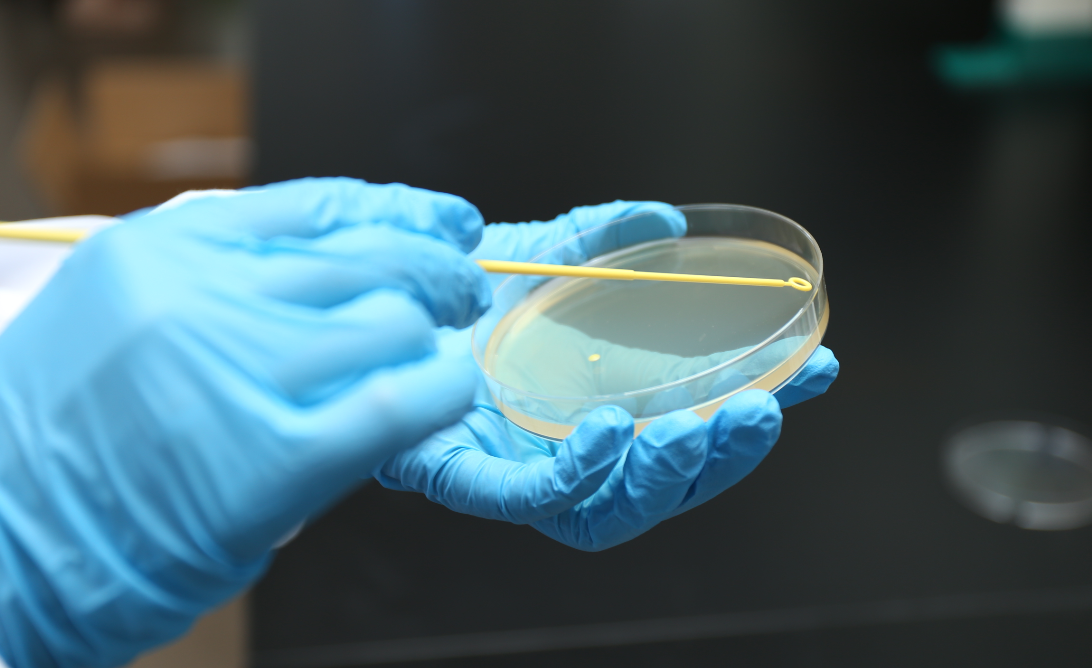
Inoculating Loop.png

Inoculation Loop with Needle 1ul 10ul
1ul 10ul
- Free Sample Port: Shanghai port Payment Type:T/T Payment Term:FOB,CIF,EXW,FCA,CPT,CIP
Product Features:
The size of the loop determines the volume of liquid an inoculation loop can transfer.they are packaged in peel-to-open paper/plastic wrappers and are sterile (gamma irradiated).
Melfu is committed to be your best choice for laboratory and medical consumables
* Used in microbiology experiments.
* Flexible handles for easier collection and inoculation.
* Sterilized by EO/ Gamma
* Easy-tear sterile packaging.
Material: AS